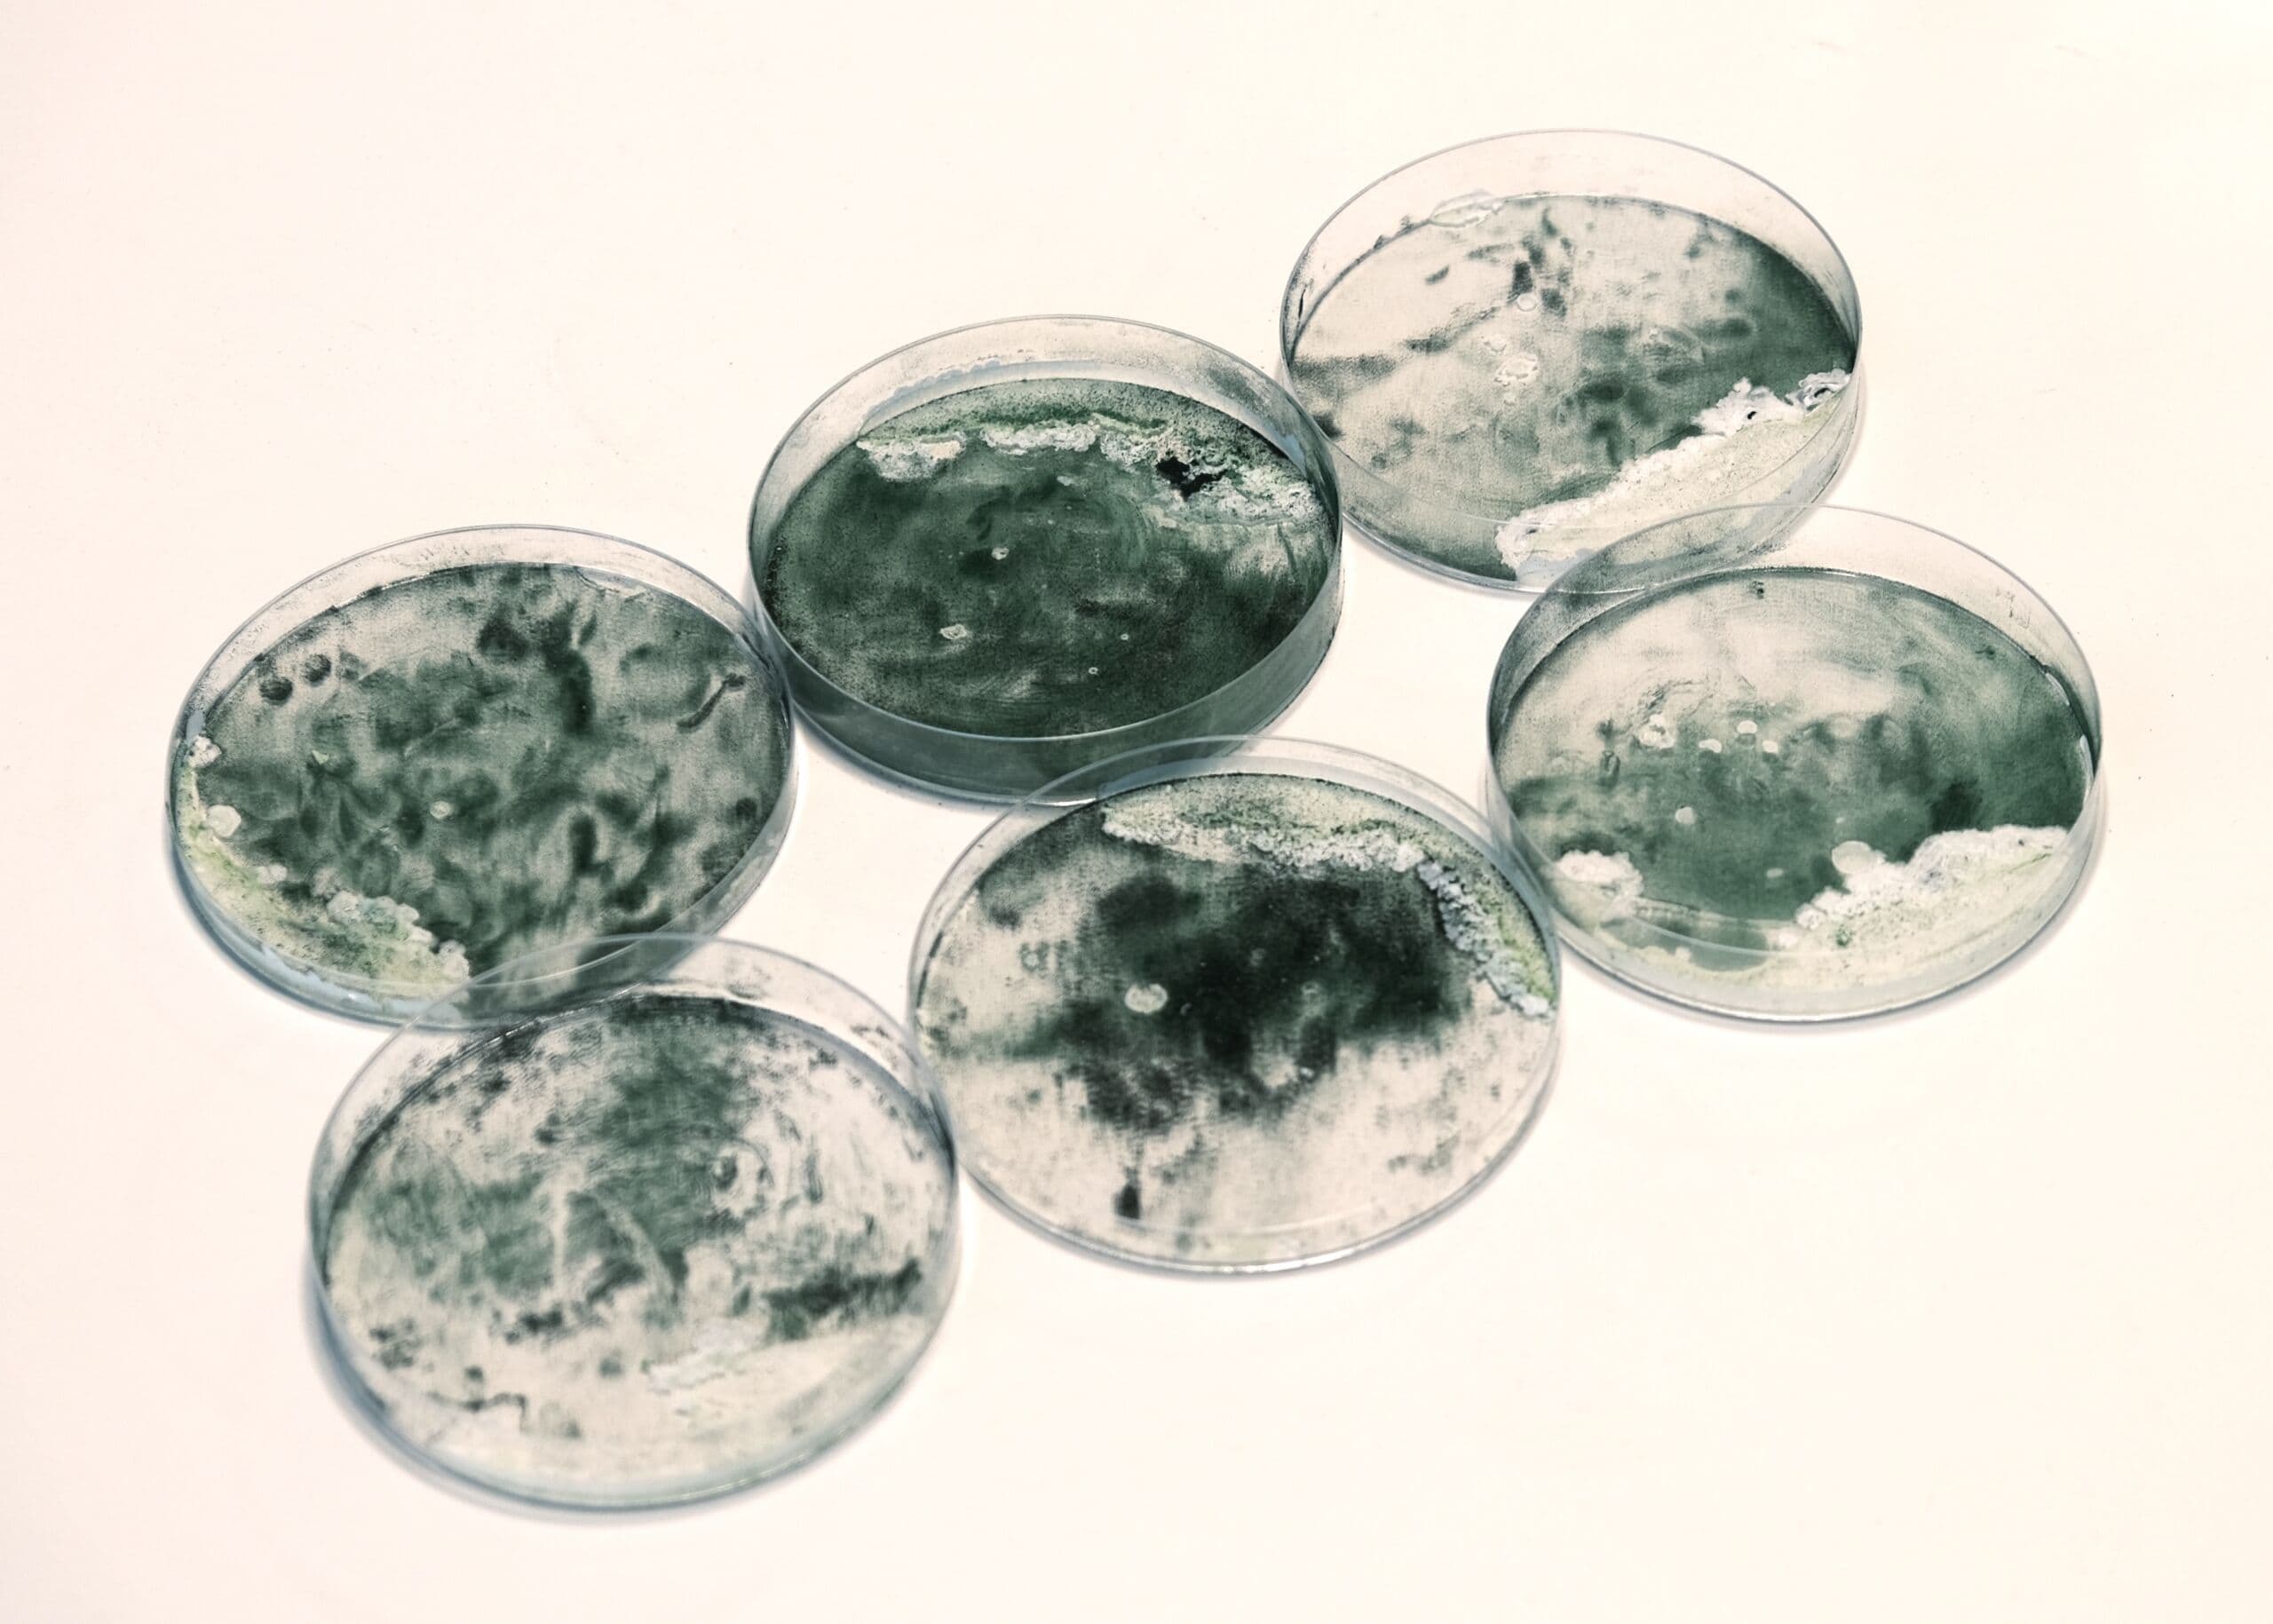
Gallery Image 4

AlgaeWave

Project Overview
Disciplines
University
Year
About
AlgaeWave introduces a groundbreaking closed-loop system that transforms noise pollution into a tool for enhancing microalgae growth. Its innovative design—comprising an aluminium tweeter, a glass resonator with steel alloy strings tuned at 400Hz, and a T-shaped connector—can be seamlessly integrated into tubular algae cultivation systems. The technology increases biomass production by 30% and reduces costs by 27%. Its modular design also ensures easy installation. AlgaeWave will enhance sustainability of applications in biofuels, biopharmaceuticals, and food production.
Team
Gallery